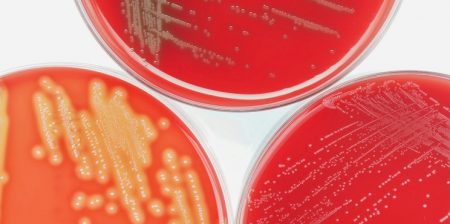

Analisi ambientale
Prevedere il rischio di scosse di assestamento in pochi secondi, grazie all'IA
Uno studio dell'Università di Edimburgo, del British Geological Survey e dell'Università di Padova suggerisce che gli strumenti di previsione dei...
PerkinElmer, successo e innovazione: l'eccellenza analitica in campo ambientale a Roma
Grande successo per l'evento dedicato alle più avanzate soluzioni per la sicurezza e la qualità ambientale, tenutosi lo scorso 25...
Dieci anni di dati Unichim: le prestazioni analitiche dei laboratori italiani operanti nel campo della qualità delle acque destinate al consumo umano e di scarico
Un’analisi unica in Europa mostra come i circuiti interlaboratorio migliorano nel tempo la qualità dei dati ambientali.
Nuovi aggiornamenti BioTrends EM: più controllo, più velocità, più affidabilità per il monitoraggio ambientale
Biotrends è lieta di presentare i nuovi aggiornamenti di BioTrends EM 2.6.1.0 e BioTrends EM Mobile 1.2.1.0, progettati per migliorare...
Ecomondo 2025, l’edizione più internazionale di sempre: la sostenibilità guida il futuro globale
Nell'edizione 2025 +7% di presenze totali, salgono del 10% quelle estere. La visita del ministro Pichetto Fratin: “Ecomondo simbolo di...
Agricoltura: il microbioma del suolo e delle radici “alleati” degli ulivi contro la siccità
Uno studio ENEA, Cnr e università di Milano, Torino e Tuscia rivela come i batteri del suolo aiutano le piante...
Making Cosmetics 2025: dove innovazione e sostenibilità diventano bellezza
Dal 19 al 20 novembre 2025, Milano ospita Making Cosmetics, l’evento professionale che unisce tutta la filiera cosmetica, dalla formulazione...
Lancio del sistema di automazione intelligente Biotage® PrepXpert-8 per la preparazione dei campioni
Biotage è entusiasta di presentare il Biotage® PrepXpert-8, un sistema di preparazione dei campioni a 8 canali completamente automatizzato, progettato...
Prove interlaboratorio Unichim per la misurazione di sostanze organiche volatili (VOC) nella matrice aria
AIR-VOCA, AIR-VOFI e AIR-VOTD, le prove valutative organizzate dall'Associazione sui VOC nell'aria ambiente, negli ambienti di lavoro e sui flussi...
40 anni di Restek: una tradizione di innovazioni, una rotta per il futuro
Restek è lieta di festeggiare il suo 40° anniversario, che segna quattro decenni di innovazione, qualità e comunità nel settore della...
Flir ed Extech ampliano l’offerta di strumenti di misura e collaudo
Flir, insieme a Extech Instruments, ha annunciato oggi il lancio di diversi nuovi strumenti progettati per offrire ai professionisti tecnici...
Agricoltura, dalle alghe un idrogel che fa crescere le piante a impatto zero
Dall'Università di Bolzano e dall'IIT arriva un aiuto contro siccità e inquinamento che supporterà le colture, un’impalcatura superassorbente in biopolimeri...
Ecomondo 2025: innovazione e strategie per la transizione ecologica
Con oltre 1.700 brand internazionali e 166.000 m² di area espositiva, la manifestazione rappresenta il cuore pulsante dell’innovazione sostenibile: una...
Idrogeno verde, parte dalla FEM un progetto innovativo per la tracciabilità
Tracciare l’origine con le analisi isotopiche, distinguendo l’idrogeno verde prodotto da fonti rinnovabili da quello fossile: è quanto si propone...
Osservare i terremoti nel luogo in cui si verificano: in Svizzera una “finestra” sulla faglia
Costruito nel laboratorio sotterraneo BedrettoLab dell'ETH di Zurigo, il tunnel che corre parallelo a una faglia naturale nelle Alpi Svizzere...
Hach ti aiuta a rinnovare la strumentazione per il monitoraggio della qualità dell’acqua con soluzioni all’avanguardia
Hach propone una promozione dedicata ai professionisti del settore ambientale e ai laboratori che desiderano aggiornare la propria strumentazione per...
I ghiacciai svelano i segreti dei vulcani: il loro ritiro potrebbe prevedere le eruzioni
Una nuova ricerca dell'Università di Torino fornisce una valutazione globale degli effetti vulcanici sul bilancio di massa dei ghiacciai, evidenziando...
Prodotti sostenibili per ogni laboratorio
Sartorius in prima linea per la riduzione dell’impatto ambientale. Tutte le innovative soluzioni Sartorius per il laboratorio sono realizzate adottando...
Dalla ricerca arriva Aqualis, una soluzione innovativa per la pulizia della acque marine
Tra gli obiettivi fondamentali della collaborazione tra il Dipartimento di Scienze dell’Università degli Studi “Gabriele d’Annunzio” di Chieti-Pescara e l'azienda...
Convalida dei metodi microbiologici con OQLAB
Semplifica la convalida dei metodi microbiologici e il controllo qualità in ambito ambientale e alimentare, gestendo incertezza, precisione e conformità...
Salvaguardia dei coralli: una biopasta conduttiva è la nuova frontiera per il restauro
Dalla collaborazione tra Università di Milano-Bicocca, Istituto Italiano di Tecnologia e Acquario di Genova arrivano soluzioni innovative per la conservazione...
IA e satelliti per scoprire discariche abusive con il 90% di precisione
Dal Politecnico di Milano un sistema innovativo che sfrutta i più recenti progressi dell'Intelligenza Artificiale nei campi della visione artificiale...
Riparte la campagna di ISPRA / CNR-IRBIM, occhi aperti in mare per scovare gli alieni invasivi
“Attenti a quei 4!” fornisce anche indicazioni utili per riconoscere le specie invasive, prevenire spiacevoli incidenti e contribuire al monitoraggio...
Al via il primo servizio climatico per l'Europa
Nell’ambito del progetto europeo CoCliCo, ENEA fornisce al servizio climatico mappe di inondazione da risalita del livello del mare per...
Effetti del fumo sulla mucosa respiratoria: l'innovazione dietro l'utilizzo delle membrane elettrofilate
L’approfondimento, presentato a LAB Italia 2025, è a cura della dott.ssa Adelaide Carista, Segretario del “Direttivo Giovani" della SIBS, Società Italiana di Biologia...
Batteri “buoni” e piante per bonificare i terreni inquinati
Il cuore del progetto Return è la bioaugmentation, ovvero l’introduzione nel suolo di 11 ceppi batterici nativi in grado di...
Ambiente: ENEA nel progetto UE da 5,6 milioni di euro per allerte incendi, ondate di calore e inquinamento
healthRiskADAPT svilupperà strumenti digitali "su misura" e punterà inoltre a rafforzare la capacità di risposta del sistema sanitario europeo alle...
Recupero dell’acetato di cellulosa dai mozziconi di sigaretta
I mozziconi di sigaretta rappresentano una delle forme più diffuse di rifiuto urbano a livello globale. Ogni anno ne vengono...
Come in Europa, anche in Italia nuovo record di caldo: +1,33 °C
Surplus di pioggia al Nord (+38%), siccità al Sud e Isole, il mare sempre più caldo con picchi di temperatura...
Acqua ultrapura per analisi sensibili dei PFAS
Quando si tratta di analisi sensibili dei PFAS, la qualità dell’acqua diventa ancora più cruciale. Anche minime tracce di contaminanti...